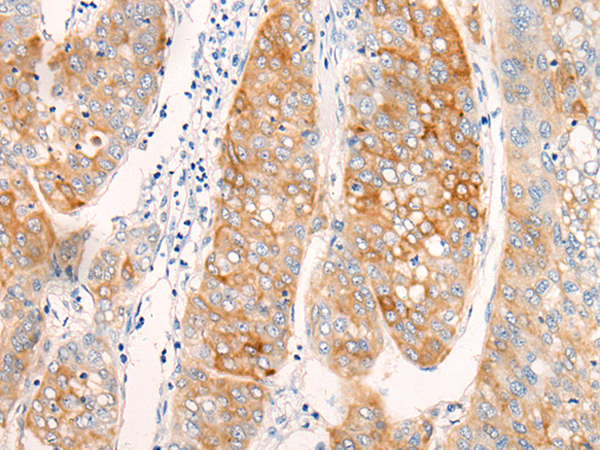

抗 原: AIFM2
宿 主: Rabbit
反應(yīng)種屬: Human, Mouse
相關(guān)類別: 一抗
標(biāo) 記 物: Unconjugate
克隆類型: rabbit polyclonal
技術(shù)規(guī)格
|
Background: |
This gene encodes a flavoprotein oxidoreductase that binds single stranded DNA and is thought to contribute to apoptosis in the presence of bacterial and viral DNA. The expression of this gene is also found to be induced by tumor suppressor protein p53 in colon cancer cells. |
|
Applications: |
ELISA, IHC |
|
Name of antibody: |
AIFM2 |
|
Immunogen: |
Synthetic peptide of human AIFM2 |
|
Full name: |
apoptosis inducing factor, mitochondria associated 2 |
|
Synonyms: |
AMID; PRG3 |
|
SwissProt: |
Q9BRQ8 |
|
ELISA Recommended dilution: |
5000-10000 |
|
IHC positive control: |
Human liver cancer |
|
IHC Recommend dilution: |
20-100 |
購物車
購物車 幫助
幫助
 021-54845833/15800441009
021-54845833/15800441009
